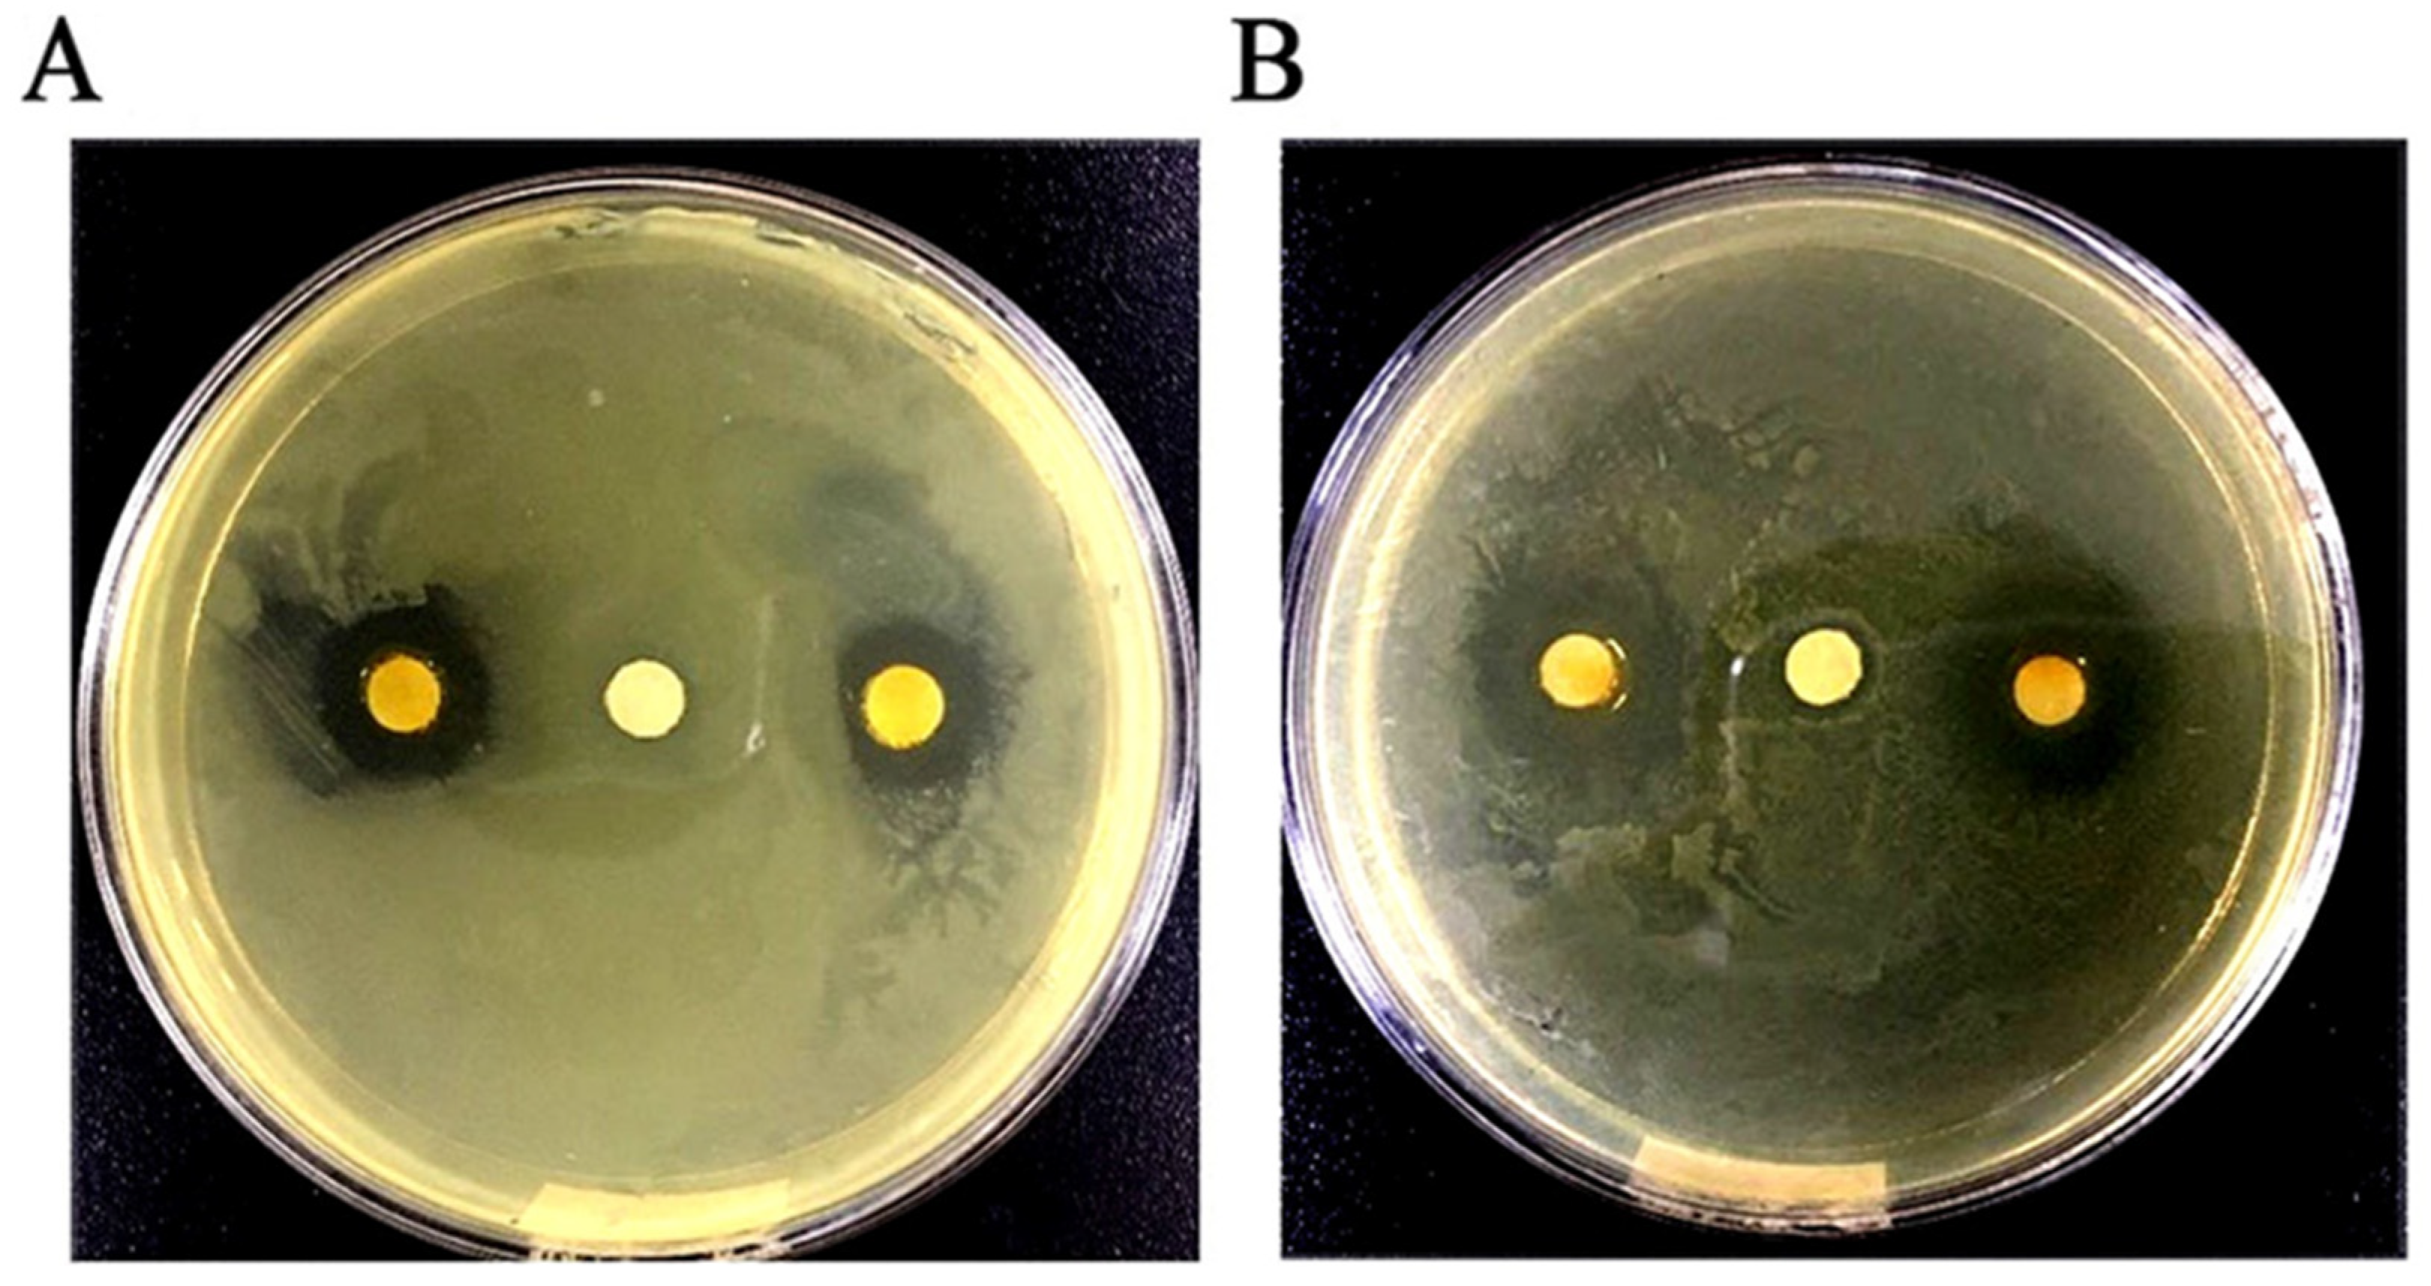

Antibacterial Activity and Mechanism of Ginger Essential Oil against Escherichia coli and Staphylococcus aureus
Abstract
1. Introduction
2. Results
2.1. Chemical Component Analysis of GEO
2.2. Antibacterial Activity
2.2.1. Determination of DIZ, MIC, and MBC in GEO against Test Microorganisms
2.2.2. Bacterial Growth Curve Analysis
2.3. Antibacterial Mechanism
2.3.1. Membrane Potential
2.3.2. SDS-PAGE Electrophoresis of the Bacterial Proteins
2.3.3. Determination of Bacterial Cell Proteins Concentration
2.3.4. Effect of GEO on cell Membrane Integrity
2.3.5. Effect of GEO on the Bacteria Lysis-Related Gene Expression
3. Discussion
4. Materials and Methods
4.1. Microorganisms and Plant Material
4.2. Extraction of Essential Oils
4.3. Chemical Composition Analysis by Gas Chromatography-Mass Spectrometry (GC-MS)
4.4. Antibacterial Activity
4.4.1. Agar Diffusion Assay
4.4.2. Determination of Minimum Inhibitory Concentration (MIC) and Minimum Bactericide Concentration (MBC)
4.4.3. Bacterial Growth Curves
4.5. Antibacterial Mechanism
4.5.1. Effect of GEO on the Membrane Potential (MP)
4.5.2. SDS-PAGE Electrophoresis of the Bacterial Cell Proteins
4.5.3. Determination of Bacterial Cell Proteins Concentration
4.5.4. Effect of GEO on Cell Membrane Integrity
4.5.5. RNA Extraction and Real-Time PCR
4.6. Statistical Analysis
5. Conclusions
Supplementary Materials
Author Contributions
Funding
Conflicts of Interest
References
- Lei, H.; Wei, Q.N.; Wang, Q.; Su, A.X.; Xue, M.; Liu, Q.; Hu, Q.H. Characterization of ginger essential oil/palygorskite composite (GEO-PGS) and its anti-bacteria activity. Mater. Sci. Eng. C. 2017, 73, 381–387. [Google Scholar] [CrossRef] [PubMed]
- De Jesus, G.S.; Micheletti, A.C.; Padilha, R.G.; de Souza de Paula, J.; Alves, F.M.; Leal, C.R.B.; Garcez, F.R.; Garcez, W.S.; Yoshida, N.C. Antimicrobial Potential of Essential Oils from Cerrado Plants against Multidrug-Resistant Foodborne Microorganisms. Molecules 2020, 25, 3296. [Google Scholar] [CrossRef] [PubMed]
- Wood, T.K. Insights on Escherichia coli biofilm formation and inhibition from whole-transcriptome profiling. Environ. Microbiol. 2010, 11, 1–15. [Google Scholar] [CrossRef] [PubMed]
- Cui, H.Y.; Zhang, C.H.; Li, C.Z.; Lin, L. Antibacterial mechanism of oregano essential oil. Ind. Crops Prod. 2019, 139, 111498. [Google Scholar] [CrossRef]
- Xu, J.G.; Liu, T.; Hu, Q.P.; Cao, X.M. Chemical composition, antibacterial properties and mechanism of action of essential oil from clove buds against Staphylococcus aureus. Molecules 2016, 21, 1194. [Google Scholar] [CrossRef] [PubMed]
- Kumar, A.; Dubey, N.K.; Srivastava, S. Antifungal evaluation of Ocimum sanctum essential oil against fungal deterioration of raw materials of Rauvolfia serpentina during storage. Ind. Crops Prod. 2013, 45, 30–35. [Google Scholar] [CrossRef]
- Falleh, H.; Ben Jemaa, M.; Saada, M.; Ksouri, R. Essential oils: A promising eco-friendly food preservative. Food Chem. 2020, 330, 127268. [Google Scholar] [CrossRef]
- Shukla, A.; Naik, S.N.; Goud, V.V.; Das, C.D. Supercritical CO2 extraction and online fractionation of dry ginger for production of high-quality volatile oil and gingerols enriched oleoresin. Ind. Crops Prod. 2019, 130, 352–362. [Google Scholar] [CrossRef]
- Da Silva Moura, E.; D’Antonino Faroni, L.R.; Fernandes Heleno, F.; Aparecida Zinato Rodrigues, A.; Figueiredo Prates, L.H.; Lopes Ribeiro de Queiroz, M.E. Optimal Extraction of Ocimum basilicum Essential Oil by Association of Ultrasound and Hydrodistillation and Its Potential as a Biopesticide against a Major Stored Grains Pest. Molecules 2020, 25, 2781. [Google Scholar] [CrossRef]
- Jayasena, D.D.; Jo, C. Essential oils as potential antimicrobial agents in meat and meat products: A review. Trends Food Sci. Technol. 2013, 34, 96–108. [Google Scholar] [CrossRef]
- Cui, H.Y.; Zhang, C.H.; Li, C.Z.; Lin, L. Antimicrobial mechanism of clove oil on Listeria monocytogenes. Food Control 2018, 94, 140–146. [Google Scholar] [CrossRef]
- Zhang, Y.B.; Liu, X.Y.; Wang, Y.F.; Jiang, P.P.; Quek, S.Y. Antibacterial activity and mechanism of cinnamon essential oil against Escherichia coli and Staphylococcus aureus. Food Control 2016, 59, 282–289. [Google Scholar] [CrossRef]
- Alsherbiny, M.A.; Abd-Elsalam, W.H.; El Badawy, S.A.; Taher, E.; Fares, M.; Torres, A.; Chang, D.; Li, C.G. Ameliorative and protective effects of ginger and its main constituents against natural, chemical and radiation-induced toxicities: A comprehensive review. Food chem. Toxicol. 2019, 123, 72–97. [Google Scholar] [CrossRef] [PubMed]
- Kieliszek, M.; Edris, A.; Kot, A.M.; Piwowarek, K. Biological Activity of Some Aromatic Plants and Their Metabolites, with an Emphasis on Health-Promoting Properties. Molecules 2020, 25, 2478. [Google Scholar] [CrossRef] [PubMed]
- Mesomo, M.C.; Corazza, M.L.; Ndiaye, P.M.; Dalla Santab, O.R.; Cardozoc, L.; Scheer, A.D.P. Supercritical CO2 extracts and essential oil of ginger (Zingiber officinale R.): Chemical composition and antibacterial activity. J. Supercrit. Fluid. 2013, 80, 44–49. [Google Scholar] [CrossRef]
- Mahboubi, M. Zingiber officinale Rosc. essential oil, a review on its composition and bioactivity. Clin. Phytosci. 2019, 5, 6. [Google Scholar] [CrossRef]
- Ju, J.; Xie, Y.F.; Guo, Y.H.; Cheng, Y.L.; Qian, H.; Yao, W.R. Application of edible coating with essential oil in food preservation. Crit. Rev. Food Sci. Nutr. 2018, 15, 2467–2480. [Google Scholar] [CrossRef]
- Hu, J.; Zhang, Y.D.; Xiao, Z.B.; Wang, X.G. Preparation and properties of cinnamon-thyme-ginger composite essential oil nanocapsules. Ind. Crops Prod. 2018, 122, 85–92. [Google Scholar] [CrossRef]
- Noori, S.; Zeynali, F.; Almasi, H. Antimicrobial and antioxidant efficiency of nanoemulsion-based edible coating containing ginger (Zingiber officinale) essential oil and its effect on safety and quality attributes of chicken breast fillets. Food Control 2018, 84, 312–320. [Google Scholar] [CrossRef]
- Teerarak, M.; Laosinwattana, C. Essential oil from ginger as a novel agent in delaying senescence of cut fronds of the fern (Davallia solida (G. Forst.) Sw.). Postharvest Biol. Tec. 2019, 156, 110927. [Google Scholar] [CrossRef]
- Del Carmen Beristain-Bauza, S.; Hernández-Carranza, P.; Soledad Cid-Pérez, T.; Ávila-Sosa, R.; Israel Ruiz-López, I.; Enrique Ochoa-Velasco, C. Antimicrobial Activity of Ginger (zingiber officinale) and Its Application in Food Products. Food Rev. Int. 2019, 41, 1–20. [Google Scholar]
- Bhavya, M.L.; Ravi, R.; Madhava Naidu, M. Development and validation of headspace Solid-Phase microextraction coupled with gas chromatography (HS-SPME-GC) method for the analysis of zingiber zerumbetL. Nat. Prod. Res. 2019, 1, 1–5. [Google Scholar] [CrossRef]
- Singh, G.; Fapoor, I.P.S.; Shigh, P.; Heluani, C.S.; Lampasona, M.P.; Catalan, C.A.N. Chemistry, Antioxidant and Antimicrobial Investigations on Essential Oil and Oleoresins of Zingiber Officinale. Food Chem. Toxicol. 2008, 46, 3295–3302. [Google Scholar] [CrossRef] [PubMed]
- Bajpai, V.K.; AL-Reza, S.M.; Choi, U.K.; Lee, J.H.; Kang, S.C. Chemical composition, antibacterial and antioxidant activities of leaf essential oil and extracts of Metasequioa glyptostroboides Miki ex Hu. Food Chem. Toxicol. 2009, 47, 1876–1883. [Google Scholar] [CrossRef] [PubMed]
- Zhang, L.L.; Zhang, L.F.; Hu, Q.P.; Hao, D.L.; Xu, J.G. Chemical composition, antibacterial activity of Cyperus rotundus rhizomes essential oil against Staphylococcus aureus via membrane disruption and apoptosis pathway. Food Control 2017, 80, 290–296. [Google Scholar] [CrossRef]
- Ju, J.; Xie, Y.F.; Guo, Y.H.; Cheng, Y.L.; Qian, H.; Yao, W.R. The inhibitory effect of plant essential oils on foodborne pathogenic bacteria in food. Crit. Rev. Food Sci. Nutr. 2018, 59, 3281–3292. [Google Scholar] [CrossRef]
- Ben Hsouna, A.; Trigui, M.; Ben Mansour, R.; Mezghani Jarraya, R.; Damak, M.; Jaoua, S. Chemical composition, cytotoxicity effect and antimicrobial activity of Ceratonia siliqua essential oil with preservative effects against Listeria inoculated in minced beef meat. Int. J. Food Microbiol. 2011, 148, 66–72. [Google Scholar] [CrossRef]
- Cho, J.; Choi, H.; Lee, J.; Kim, M.S.; Sohn, H.Y.; Lee, D.G. The antifungal activity and membrane-disruptive action of dioscin extracted from Dioscorea nipponica. Biochim. Biophys. Acta 2013, 1828, 1153–1158. [Google Scholar] [CrossRef]
- Novo, D.; Perlmutter, N.G.; Hunt, R.H.; Shapiro, H.M. Accurate flow cytometric membrane potential measurement in bacteria using diethyloxacarbocyanine and a ratiometric technique. Cytometry 1999, 35, 55–63. [Google Scholar] [CrossRef]
- Cui, H.; Bai, M.; Sun, Y.; Abdel-Samie, M.A.; Lin, L. Antibacterial activity and mechanism of Chuzhou chrysanthemum essential oil. J. Funct. Foods 2018, 48, 159–166. [Google Scholar] [CrossRef]
- Hu, F.; Tu, X.F.; Thakur, K.; Hu, F.; Li, X.L.; Zhang, Y.S.; Zhang, J.G.; Wei, Z.J. Comparison of antifungal activity of essential oils from different plants against three fungi. Food Chem. Toxicol. 2019, 134, 110821. [Google Scholar] [CrossRef] [PubMed]
- Wang, L.Q.; Hu, W.; Deng, J.; Liu, X.; Zhou, J.; Li, X.Z. Antibacterial activity of Litsea cubeba essential oil and its mechanism against Botrytis cinerea. RSC Adv. 2019, 9, 28987–28995. [Google Scholar] [CrossRef]
- Rhayour, K.; Bouchikhi, T.; Tantaoui-Elaraki, A.; Sendide, K.; Remmal, A. The mechanism of bactericidal action of oregano and clove essential oils and of their phenolic major components on Escherichia coli and Bacillus subtilis. J. Essent. Oil Res. 2003, 15, 356–362. [Google Scholar] [CrossRef]
- Meira, N.; Holley, R.A.; Bordin, K.; Macedo, R.; Luciano, F.B. Combination of essential oil compounds and phenolic acids against Escherichia coli O157: H7 in vitro and in dry-fermented sausage production. Int. J. Food Microbiol. 2017, 260, 59–64. [Google Scholar] [CrossRef]
- Watson, A.L.; Chiu, N.H. Fluorometric cell-based assay for β-galactosidase activity in probiotic gram-positive bacterial cells-Lactobacillus helveticus. J. Microbiol. Meth. 2016. 128, 58–60. [CrossRef]
- Zhang, Y.Y.; Zhang, F.; Zhang, Y.S.; Thakur, K.; Zhang, J.G.; Liu, Y.; Kan, H.; Wei, Z.J. Mechanism of juglone-induced cell cycle arrest and apoptosis in ishikawa human endometrial cancer cells. J. Agric. Food Chem. 2019, 67, 7378–7389. [Google Scholar] [CrossRef]
- Muthaiyan, A.; Martin, E.M.; Natesan, S.; Crandall, P.G.; Wilkinson, B.J.; Ricke, S.C. Antimicrobial effect and mode of action of terpeneless cold-pressed Valencia orange essential oil on methicillin-resistant staphylococcus aureus. J. Appl. Microbiol. 2012, 112, 1020–1033. [Google Scholar] [CrossRef]
- Ma, Y.L.; Zhu, D.Y.; Thakur, K.; Wang, C.H.; Wang, H.; Ren, Y.F.; Zhang, J.G.; Wei, Z.J. Antioxidant and antibacterial evaluation of polysaccharides sequentially extracted from onion (Allium cepa L.). Int. J. Biol. Macromol. 2018, 111, 92–101. [Google Scholar] [CrossRef]
- Tu, X.F.; Hu, F.; Thakura, K.; Li, X.L.; Zhang, Y.S.; Wei, Z.J. Comparison of antibacterial effects and fumigant toxicity of essential oils extracted from different plants. Ind. Crops Prod. 2018, 124, 192–200. [Google Scholar] [CrossRef]
- Cassel, E.; Vargas, R.M.F.; Martinez, N.; Lorenzob, D.; Dellacassa, E. Steam distillation modeling for essential oil extraction process. Ind. Crops Prod. 2009, 29, 171–176. [Google Scholar] [CrossRef]
- Wei, C.K.; Ni, Z.J.; Thakura, K.; Liao, A.M.; Huang, J.H.; Wei, Z.J. Aromatic effects of immobilized enzymatic oxidation of chicken fat on flaxseed (Linum usitatissimum L.) derived Maillard reaction products. Food Chem. 2020, 306, 125560. [Google Scholar] [CrossRef] [PubMed]
- Dong, G.; Bai, X.; Aimila, A.; Aisa, H.A.; Maiwulanjiang, M. Study on Lavender Essential Oil Chemical Compositions by GC-MS and Improved pGC. Molecules 2020, 25, 3166. [Google Scholar] [CrossRef] [PubMed]
- Pirbalouti, A.G.; Izadi, A.; Poor, F.M.; Hamedi, B. Chemical composition, antioxidant and antibacterial activities of essential oils from Ferulago angulate. Pharm. Biol. 2016, 54, 2515–2520. [Google Scholar] [CrossRef] [PubMed]
- Shu, Q.; Niu, Y.W.; Zhao, W.J.; Chen, Q.H. Antibacterial activity and mannosylerythritol lipids against vegetative cells and spores of Bacillus cereus. Food Control 2019, 106, 106711. [Google Scholar] [CrossRef]
- Huang, M.X.; Yu, X.Q.; Ye, Y. A Study of Fibrin Zymography Method for the Assay of Plasminogen Activators. Adv. Mater. Res. 2012, 569, 789–794. [Google Scholar] [CrossRef]
- Wang, C.J.; Chang, T.; Yang, H.; Cui, M. Antibacterial mechanism of lactic acid on physiological and morphological properties of Salmonella Enteritidis, Escherichia coli and Listeria monocytogenes. Food Control 2015, 47, 231–236. [Google Scholar] [CrossRef]
- Cui, H.Y.; Zhao, C.T.; Lin, L. Antibacterial activity of Helichrysum italicum oil on vegetables and its mechanism of action. J. Food Process. Preserv. 2015, 48, 159–166. [Google Scholar]
Sample Availability: Samples of the compounds of Ginger essential oil available from the authors. |

| No | RT (min) | RI | Compounds | Content (Peak area%) | |
|---|---|---|---|---|---|
| Supercritical CO2 Extraction | Steam Distillation | ||||
| 1 | 5.84 | 710 | α-Pinene | 1.934 | nd |
| 2 3 | 6.273 6.417 | 723 727 | Camphene Sabinene | 3.012 2.651 | nd nd |
| 4 | 7.039 | 745 | α-Phellandrene | 2.287 | nd |
| 5 | 8.405 | 785 | β-Phellandrene | 3.699 | 2.567 |
| 6 | 10.426 | 828 | Borneol | 0.648 | 0.279 |
| 7 8 | 13.246 16.473 | 880 932 | Farnesene β-Bisabolene | 1.145 2.643 | 1.135 2.876 |
| 9 | 18.952 | 969 | Elemene | 1.203 | 1.018 |
| 10 | 19.295 | 974 | α-Selinene | 0.901 | 1.836 |
| 11 | 20.612 | 993 | γ-Elemene | 0.721 | 1.709 |
| 12 | 21.314 | 1003 | α-Curcumene | 10.221 | 12.043 |
| 13 | 21.706 | 1009 | Zingiberene | 37.549 | 35.651 |
| 14 | 21.975 | 1013 | α-Farnesene | 3.12 | 4.52 |
| 15 | 22.396 | 1018 | Zingiberone | 6.591 | 9.023 |
| 16 | 22.98 | 1027 | Elemol | 0.902 | 1.021 |
| 17 | 33.542 | 1178 | Geraniol | 1.542 | 1.382 |
| 18 | 36.943 | 1216 | Geranialdehyde | 2.031 | 2.463 |
| 19 | 48.345 | 1544 | 6-Gingerol | 1.026 | 0.120 |
| 20 | 48.445 | 1548 | Octadecadienoic acid | 0.901 | 0.682 |
| Total | 84.727 | 78.325 | |||
| Bacterial Species | DIZ (mm) | MIC (mg/mL) | MBC (mg/mL) |
|---|---|---|---|
| E. coil | 12.3 ± 0.6 b | 2.0 | 4.0 |
| S. aureus | 17.1 ± 0.8 a | 1.0 | 2.0 |
| Time | E. coli | S. aureus | ||||
|---|---|---|---|---|---|---|
| Control | MIC | MBC | Control | MIC | MBC | |
| 2 h | 0.97 ± 0.05 a | 0.75 ± 0.04 b | 0.61 ± 0.02 c | 1.17 ± 0.21 A | 0.72 ± 0.004 B | 0.60 ± 0.08 C |
| 4 h | 3.38 ± 0.17 a | 1.97 ± 0.08 b | 1.24 ± 0.04 c | 3.59 ± 0.23 A | 2.14 ± 0.12 B | 1.21 ± 0.1 C |
| 6 h | 7.32 ± 0.29 a | 5.39 ± 0.21 b | 1.86 ± 0.05 c | 8.25 ± 0.34 A | 5.04 ± 0.32 B | 1.84 ± 0.23 C |
| 8 h | 13.32 ± 0.56 a | 9.98 ± 0.42 b | 2.51 ± 0.06 c | 15.82 ± 0.86 A | 9.84 ± 0.45 B | 2.45 ± 0.37 C |
| 10 h | 24.11 ± 0.91 a | 17.14 ± 0.68 b | 3.15 ± 0.08 c | 27.80 ± 1.45 A | 15.51 ± 1.43 B | 3.08 ± 0.28 C |
| 12 h | 40.38 ± 1.04 a | 26.77 ± 0.89 b | 3.79 ± 0.09 c | 50.97 ± 1.87 A | 24.57 ± 1.67 B | 3.72 ± 0.39 C |
| 14 h | 68.17 ± 2.01 a | 36.09 ± 1.01 b | 4.43 ± 0.12 c | 83.50 ± 2.05 A | 34.02 ± 1.83 B | 4.36 ± 0.69 C |
| 16 h | 104.8 ± 4.27 a | 42.31 ± 1.23 b | 5.08 ± 0.12 c | 152.58 ± 5.65 A | 47.97 ± 2.57 B | 4.99 ± 0.65 C |
| 18 h | 129.16 ± 5.03 a | 47.65 ± 1.78 b | 5.69 ± 0.13 c | 266.26 ± 7.01 A | 57.42 ± 3.65 B | 5.67 ± 0.59 C |
| 20 h | 143.66 ± 6.21 a | 52.99 ± 1.83 b | 6.38 ± 0.17 c | 364.16 ± 8.98 A | 66.68 ± 3.98 B | 6.338 ± 0.76 C |
| 22 h | 158.36 ± 6.82 a | 58.33 ± 2.03 b | 7.05 ± 0.16 c | 402.89 ± 9.94 A | 73.37 ± 4.97 B | 7.04 ± 0.38 C |
| 24 h | 175.07 ± 7.34 a | 65.09 ± 3.01 b | 7.69 ± 0.21 c | 441.47 ± 10.13 A | 80.05 ± 5.05 B | 7.75 ± 0.98 C |
| Time | E. coli | S. aureus | ||||
|---|---|---|---|---|---|---|
| Control | MIC | MBC | Control | MIC | MBC | |
| 2 h | 0.71 ± 0.02 a | 0.92 ± 0.03 b | 1.13 ± 0.06 c | 0.59 ± 0.02 A | 0.97 ± 0.031 B | 1.14 ± 0.13 C |
| 4 h | 0.20 ± 0.01 a | 0.35 ± 0.02 b | 0.56 ± 0.02 c | 0.19 ± 0.04 A | 0.32 ± 0.024 B | 0.56 ± 0.09 C |
| 6 h | 0.09 ± 0.005 a | 0.13 ± 0.03 b | 0.37 ± 0.01 c | 0.08 ± 0.03 A | 0.137 ± 0.004 B | 0.37 ± 0.06 C |
| 8 h | 0.05 ± 0.002 a | 0.07 ± 0.003 a | 0.28 ± 0.04 b | 0.043 ± 0.003 A | 0.07 ± 0.007 A | 0.28 ± 0.05 B |
| 10 h | 0.03 ± 0.003 a | 0.04 ± 0.012 a | 0.22 ± 0.03 b | 0.025 ± 0.006 A | 0.044 ± 0.0056 A | 0.22 ± 0.01 B |
| 12 h | 0.02 ± 0.001 a | 0.026 ± 0.01 a | 0.18 ± 0.04 b | 0.014 ± 0.0006 A | 0.0282 ± 0.004 B | 0.186 ± 0.014 C |
| 14 h | 0.01 ± 0.0005 a | 0.019 ± 0.01 a | 0.16 ± 0.01 b | 0.008 ± 0.0001 A | 0.029 ± 0.0054 B | 0.158 ± 0.031 C |
| 16 h | 0.007 ± 0.001 a | 0.016 ± 0.01 b | 0.14 ± 0.01 c | 0.0045 ± 0.0001 A | 0.0146 ± 0.004 B | 0.138 ± 0.021 C |
| 18 h | 0.005 ± 0.001 a | 0.015 ± 0.01 b | 0.12 ± 0.003 c | 0.0026 ± 0.0003 A | 0.012 ± 0.0001 B | 0.12 ± 0.014 C |
| 20 h | 0.005 ± 0.002 a | 0.013 ± 0.01 b | 0.11 ± 0.001 c | 0.0019 ± 0.0001 A | 0.01 ± 0.0002 B | 0.1 ± 0.005 C |
| 22 h | 0.004 ± 0.002 a | 0.012 ± 0.01 b | 0.10 ± 0.005 c | 0.0017 ± 0.0002 A | 0.009 ± 0.0003 B | 0.098 ± 0.004 C |
| 24 h | 0.0039 ± 0.003 a | 0.011 ± 0.003 b | 0.09 ± 0.001 c | 0.0015 ± 0.0003 A | 0.008 ± 0.0005 B | 0.089 ± 0.003 C |
© 2020 by the authors. Licensee MDPI, Basel, Switzerland. This article is an open access article distributed under the terms and conditions of the Creative Commons Attribution (CC BY) license (http://creativecommons.org/licenses/by/4.0/).
Share and Cite
Wang, X.; Shen, Y.; Thakur, K.; Han, J.; Zhang, J.-G.; Hu, F.; Wei, Z.-J. Antibacterial Activity and Mechanism of Ginger Essential Oil against Escherichia coli and Staphylococcus aureus. Molecules 2020, 25, 3955. https://doi.org/10.3390/molecules25173955
Wang X, Shen Y, Thakur K, Han J, Zhang J-G, Hu F, Wei Z-J. Antibacterial Activity and Mechanism of Ginger Essential Oil against Escherichia coli and Staphylococcus aureus. Molecules. 2020; 25(17):3955. https://doi.org/10.3390/molecules25173955
Chicago/Turabian StyleWang, Xin, Yi Shen, Kiran Thakur, Jinzhi Han, Jian-Guo Zhang, Fei Hu, and Zhao-Jun Wei. 2020. "Antibacterial Activity and Mechanism of Ginger Essential Oil against Escherichia coli and Staphylococcus aureus" Molecules 25, no. 17: 3955. https://doi.org/10.3390/molecules25173955
APA StyleWang, X., Shen, Y., Thakur, K., Han, J., Zhang, J.-G., Hu, F., & Wei, Z.-J. (2020). Antibacterial Activity and Mechanism of Ginger Essential Oil against Escherichia coli and Staphylococcus aureus. Molecules, 25(17), 3955. https://doi.org/10.3390/molecules25173955

